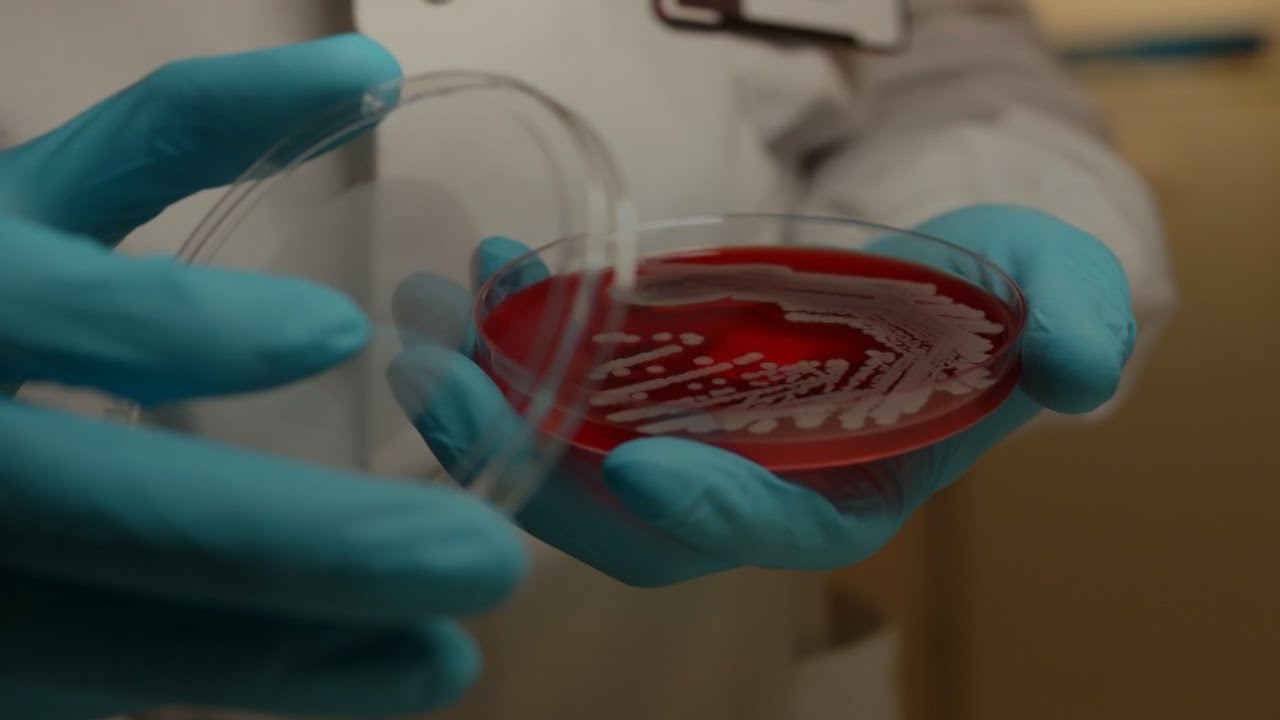

4 شهداء بنيران جيش الاحتلال في مدينتي غزة وخان يونس منذ صباح اليوم
24 نوفمبر 2025 11:46 ص
نشرت في 10 نوفمبر 2020 05:11 م
هناك العديد من الأمراض والفيروسات، النادر حدوثها، لكن عند ظهورها قد تصيب الآلاف وتودي بحياتهم، وتكون بمثابة تهديد لبقاء الجنس البشري على الأرض.
وتصدرت مرض "مارسا" النادر، محرك البحث جوجل، ليتساءل الجمهور، عن أعراضه وطرق الوقاية منه، وكيف يتم انتقال العدوى.
ويرصد هذا الفيديو، معلومات عن مرض "مارسا" النادر:
في البداية، مرض أو فيروس "مارسا" هو المكورات العنقودية المقاومة للميثيسيلن، وهي عدوى بكتيريا مقاومة للعديد من المضادات الحيوية (المضادات الحيوية لم تعد فعالة)؛ قد تسبب التهابات في الجسم.
تنتقل عدوى "مارسا" عن طريق ملامسة المصاب أو مشاركته أدواته أو في الأماكن المزدحمة، والأسطح الملوثة، والتعامل مع حيوانات حاملة لمسببات المرض، وتتواجد في الأماكن التي بها أشخاص يستخدمون المضاد الحيوي بكثرة.
ما هي أعرض "مارسا"؟
عادة ما تبدأ على شكل:تورم ونتوءات حمراء مؤلمة قد تشبه البثور أو لدغات العنكبوت.
ارتفاع درجة حرارة الجسم.
ألم ودفء المنطقة المصابة.
التهابات في بعض الأعضاء.
المضاعفات
التهابات في الجلد.
ضيق في التنفس.
التهاب رئوي.
تسمم الدم.
الفئات الأكثر عرضه للإصابة:
الأشخاص المقيمون في المستشفيات.
كبار السن.
العاملون في المجال الرعاية الصحية.
مرضى غسيل الكلى.
المصابون بضعف في الجهاز المناعي.
الأشخاص المصابون بحروق في الجلد.
طرق الوقاية:
طرق الوقاية، تكمن في غسل اليدين جيدًا بالماء والصابون.
وللعاملين في المجال الصحي يجب ارتداء الملابس الواقية. كما يجب اتباع إجراءات لنظافة اليدين.
المحافظة على تغطية وتعقيم الجروح حتى تلتئم.
تطهير الأسطح الملوثة والأشياء المستخدمة في الغسيل بشكل صحيح.
المحافظة على تنظيف الأماكن بشكل مستمر.
تجنّب مشاركة الأغراض الشخصية، مثل: "المناشف، الملاءات، شفرات الحلاقة، الملابس، المعدات الرياضية".
العلاج:
المضادات الحيوية: من خلال التعرف نوع البكتيريا المسببة للعدوى، واختيار المضاد الحيوي المناسب لها.
الجراحة: في كثير من الأحيان يحتاج المريض إلى جراحة لاستئصال الجزء المصاب.